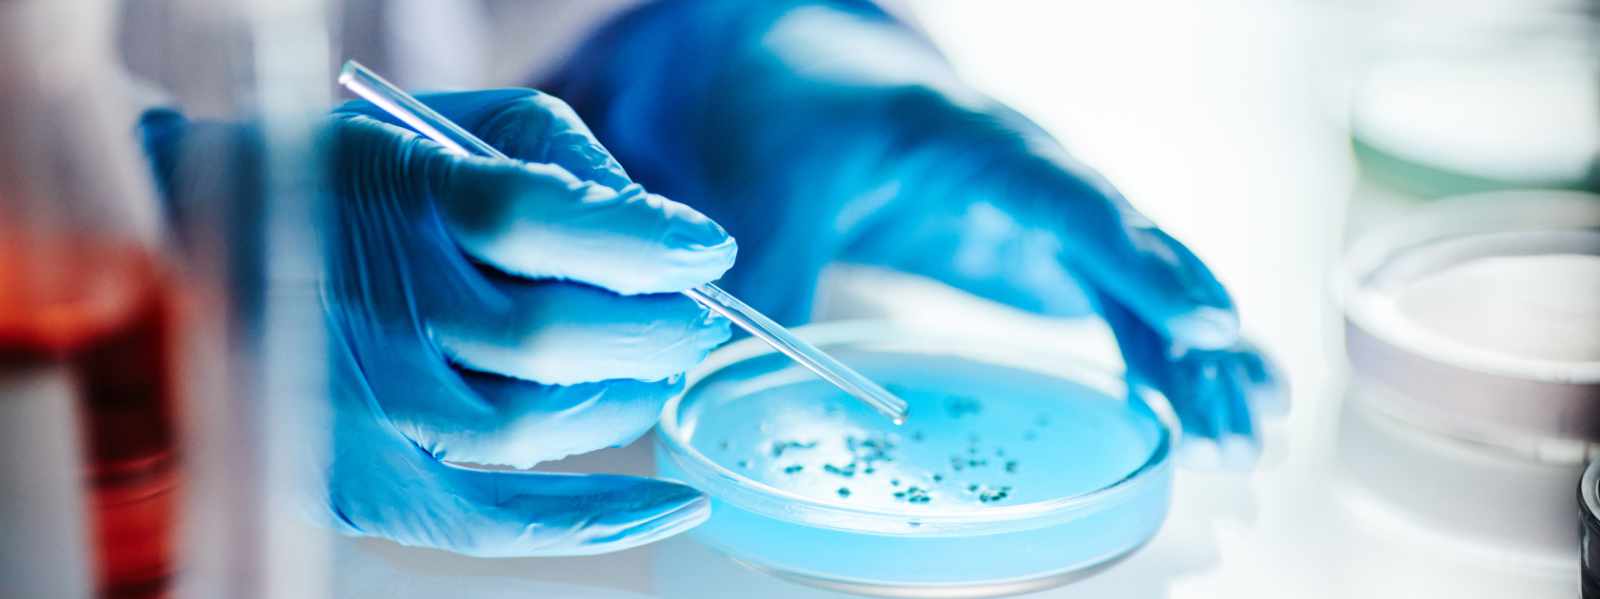
A chemist working with a petri dish in the lab

Contact the media office
News Archive

Dr Rebecca Beveridge honoured for her pioneering work.

Work co-produced by communities adversely affected by racism.

World’s largest-ever observational study of political parties across 25 African countries.

.jpg)






















































